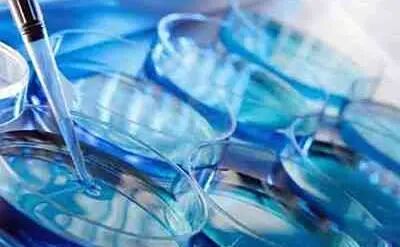

吉尔吉斯斯坦凭借较高的试管成功率和相对经济的费用,成为越来越多国际患者的选择。然而,试管婴儿的成功率受医疗技术、患者身体条件、生活习惯等多重因素影响。若想在吉尔吉斯斯坦实现高效助孕,以下6个常被忽视的细节需重点关注。
一、精准选择医疗机构
吉尔吉斯斯坦的试管婴儿机构水平参差不齐,部分诊所虽宣传“高成功率”,但设备陈旧、操作不规范。优先选择具备国际认证(如JCI)的机构,这些机构通常与欧美生殖医学中心合作,引入低氧培养箱、自动化胚胎操作仪等先进设备,且医生团队具备跨国执业经验,能根据患者年龄、卵巢储备功能制定个性化促排方案。
二、重视术前检查
术前检查是制定治疗方案的基础,但部分患者因急于进周而忽略关键指标。例如,甲状腺功能异常(如甲减)会干扰卵泡发育,导致促排药物剂量偏差;空腹血糖受损(如糖耐量异常)可能引发胚胎着床失败。吉尔吉斯斯坦某诊所数据显示,未进行糖化血红蛋白检测的患者,移植后早期流产率比规范检查者高18%。
术前需完成血常规、肝肾功能、性激素六项、AMH(抗缪勒管激素)、甲状腺功能、传染病筛查、子宫输卵管造影等基础检查,并增加空腹血糖、糖化血红蛋白、凝血功能等代谢指标检测。男性需进行精液常规、DNA碎片率分析,排除少精、弱精或精子畸形问题。
三、优化促排方案
促排卵阶段作为试管婴儿的“起点”,用药方案至关重要。固定剂量用药存在明显弊端:35岁以上女性卵巢功能衰退,若沿用年轻患者的标准剂量(如150-225IU/天),会因卵泡对药物敏感性降低导致取卵数不足;而年轻患者若剂量过高,则可能引发腹水、胸水等卵巢过度刺激综合征(OHSS)的严重并发症。因此,选择能提供“个体化促排方案”的医院,医生会结合患者基础FSH值、窦卵泡数、BMI等指标动态调整剂量,以平衡获卵数与安全性。
四、严格把控胚胎移植时机
胚胎移植时机直接影响着床率,移植前需通过B超确认子宫内膜厚度(理想范围8-12mm)、形态(A型或B型)及血流信号,并排除宫腔粘连、息肉等异常。对于反复移植失败的患者,可进行子宫内膜容受性检测(ERA),精准定位胚胎移植的“黄金窗口期”。
五、术后管理
移植后的管理是“临门一脚”,但患者常因过度紧张或忽视细节而影响结果。移植后48小时内避免剧烈运动,但无需绝对卧床,可正常散步、上下楼梯;饮食以清淡、易消化为主,增加富含纤维素的食物(如蔬菜、全谷物)预防便秘;避免接触高温环境(如桑拿)、化学污染物(如新装修房屋)及辐射源;严格遵医嘱使用黄体酮栓剂或注射剂维持黄体功能,切勿自行停药。
六、心理状态
试管婴儿周期长、不确定性高,患者易出现焦虑、抑郁等情绪,而压力激素(如皮质醇)会干扰下丘脑-垂体-卵巢轴,导致卵泡发育异常或胚胎着床失败。某医院研究发现,接受心理疏导的患者,移植后β-hCG阳性率比未干预者高22%。若出现持续失眠、情绪低落等症状,可寻求专业心理咨询师帮助。








